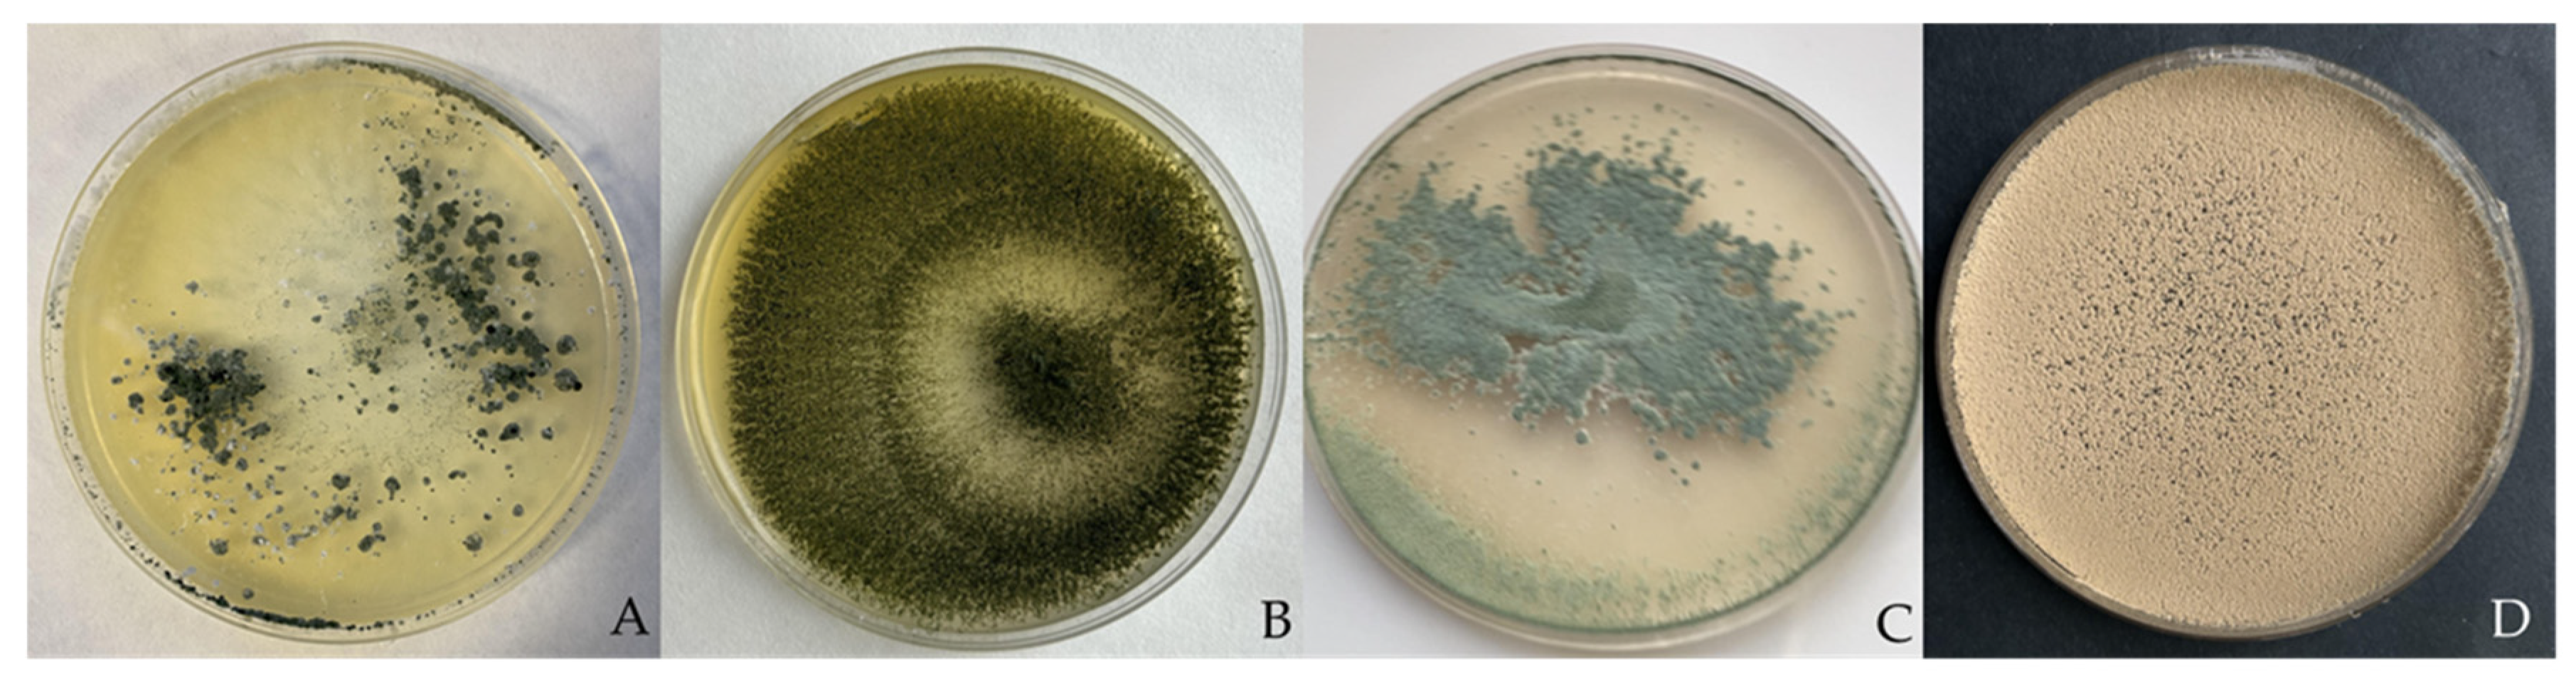
Jof 09 00360 g001

Abstract
The main objective of this study was to evaluate the ability of Trichoderma aggressivum f. europaeum, T. longibrachiatum, Paecilomyces variotii, and T. saturnisporum as biological control agents (BCAs) against diseases caused by P. capsici and P. parasitica in pepper. For this purpose, their antagonistic activities were evaluated both in vitro and in vivo. We analysed the expression patterns of five defence related genes, CaBGLU, CaRGA1, CaBPR1, CaPTI1, and CaSAR8.2, in leaves. All BCAs showed a high in vitro antagonistic activity, significantly reducing the mycelial growth of P. capsici and P. parasitica. The treatments with T. aggressivum f. europaeum, T. longibrachiatum, and P. variotii substantially reduced the severity of the disease caused by P. capsici by 54, 76, and 70%, respectively, and of the disease caused by P. parasitica by 66, 55, and 64%, respectively. T. saturnisporum had the lowest values of disease reduction. Reinoculation with the four BCAs increased the control of both plant pathogens. Markedly different expression patterns were observed in the genes CaBGLU, CaRGA1, and CaSAR8.2. Based on the results, all four BCAs under study could be used as a biological alternative to chemicals for the control of P. capsici and P. parasitica in pepper with a high success rate.
1. Introduction
The genus Phytophthora includes a group of devastating plant pathogenic species that economically affect important crops worldwide. This genus has long been included in the family Pythiaceae, within the group of oomycetes, but was ultimately included in the family Peronosporaceae after ribosomal analysis [1,2]. Advances in molecular analysis have enabled the elucidation of these issues and the description of new genera such as Phytopythium [3,4,5,6,7]. Currently, a total of 365 species and subspecies have been described (www.mycobank.org, accessed on 2 May 2022) in the genus Phytophthora, and this number continues to increase [5,8,9,10,11,12]. These species are classified into 12 phylogenetic clades [13,14,15], and new species of Phytophthora hybrids have been recently identified [16,17,18,19].
A number of species in this genus have been characterised as pathogenic in plants, which have a wide range of hosts. P. capsici Leonian and P. parasitica Dastur (syn. P. nicotianae Breda de Haan) are the most important pathogenic species of the genus for pepper (Capsicum annuum) crops in Spain [20,21]. Phytophthora capsici causes root rot, crown rot, foliar blight, and fruit rot in pepper [22]; P. parasitica is a causal agent of root and crown rot [20]. Due to the similarities of the symptoms on the roots and crown, both species may cause diagnostic confusion. The symptoms considerably vary according to the host, areas of infection, and environmental conditions, such as soil, air, and water temperature [23,24]. Methods of Phytophthora control include cultivation practices, fungicide application, and the use of resistant or tolerant varieties [25,26]. Control in many vegetable-growing areas in Spain has been based on the use of chemical soil disinfectants, many of which have been banned [27]. Currently, only a few fungicides are authorised for Phytophthora control, and their effectiveness is not guaranteed. In addition, they often generate resistance; for example, the resistance of P. capsici to metalaxyl [26,28,29]. Furthermore, the ability of Phytophthora to overcome the genetic resistance of plants owing to its genetic variability creates the need for alternative control methods for both diseases. Different cultivation techniques, such as grafting on resistant rootstocks [30,31,32,33,34] or nonchemical disinfection methods [35,36,37,38,39,40,41,42,43], have been used as alternatives. Crop rotation is a key component in the integrated management of diseases caused by Phytophthora; nevertheless, the survival of oospores, even in the absence of hosts, limits the effectiveness of these methods [21,44].
In recent years, different studies have been conducted by combining biological and chemical control agents (BCAs and CCAs, respectively) and/or combining the techniques mentioned above [45]. Reduced doses of fungicide stress and weaken the pathogen, increasing its susceptibility to attack by the antagonist [46]. BCAs are alternatives or complements to CCAs. CCAs are also adversely affected by the application of microbial antagonists because these antagonists are harmed by the application of pesticides, such that their effectiveness is sometimes weakened [47]. Biodisinfection and the subsequent incorporation of antagonistic bacteria and/or fungi may increase the benefits of this practice. For example, Wang et al. [48] demonstrated that combining biofumigation with the addition of Bacillus amyloliquefaciens controlled the disease caused by P. capsici by 40% to 90% in peppers. Other authors also described the benefits of the combined action of biofumigation and microbial incorporation [49].
Many microorganisms are growth inhibitors of P. capsici and P. parasitica, including Streptomyces spp. [50,51,52,53,54,55,56,57], Bacillus spp. [58,59,60,61,62,63,64,65], Paenibacillus spp. [66], Pseudomonas spp. [67,68], Rhizobium spp. [69], Serratia spp. [63,70], Trichoderma spp. [68,71,72,73,74,75,76,77], Aspergillus spp. [78,79], Penicillium spp. [80], Curvularia spp. [81], Clitocybe nuda [82], Cladobotryum mycophilum [83], Fusarium solani [68], Aureobasidium pullulans [84], Rhodotorula mucilaginosa [85], Muscodor albus [86], mycorrhizal fungi [87], and mixtures of microorganisms [88,89,90,91,92,93,94]. The mechanisms used for their control include the production of lytic enzymes, volatile and non-volatile active metabolites, mycoparasitism, competition for nutrients and space, and host resistance induction [75,95,96,97,98,99,100,101]. Similarly, soil bioactivation through the incorporation of microorganisms could reduce pathogen counts through the indirect effect of an optimised soil microbiome that improved the nonbiological factors of the soil [45]. Moreover, the rhizosphere microbiome plays a substantial role in reprogramming the defence responses of plants [102].
Plants recognise the presence of pathogens through interactions with receptors known as pathogen- and microbe-associated molecular patterns (PAMPs and MAMPs, respectively), inducing a local defence response termed PAMP-triggered immunity [103,104,105]. Some pathogens, including oomycetes, can suppress this response [105,106], which can be counteracted by cytoplasmic receptors (resistance proteins). These receptors, in turn, trigger a defence response termed effector-triggered immunity, which generates a hypersensitive response [105]. In addition to triggering local responses, plant pathogens induce systemic responses or systemic acquired resistance (SAR), such as Fusarium oxysporum fsp. lycopersici [107] and nonhost Phytophthora nicotianae [108], both of which protect pepper plants from subsequent infection with P. capsici. In addition to pathogens, numerous beneficial microorganisms trigger these immune responses [109,110]. Accordingly, systemic resistance against different Phytophthora species can be induced by Trichoderma [111,112,113,114,115], Bacillus velezensis [116], B. subtilis [115,117], B. thuringiensis [118], B. vallismortis [119], B. amyloliquefaciens [120], Burkholderia sp. [121], and the microorganisms present in aqueous compost extracts [122], among many others. The differential expression of genes involved in plant defence mechanisms allows us to compare how plants defend themselves against attack by different pathogens. Other control systems against Phytophthora include the inhibitory effect of extracellular self-DNA, which acts as a damage-associated molecular pattern (DAMP) on the pathogen, affecting the germination rate of P. capsici zoospores, thereby protecting the plant [123]. This type of technology should be studied in depth for subsequent applications in agriculture.
Pepper (Capsicum annuum L.) is the most important vegetable crop in Almeria, south-eastern Spain, covering 12,310 ha of cultivated land. In the 2020/2021 crop year, the total pepper production was 1,508,168 t, reflecting a 63.5% increase in the area of land cultivated with peppers in the last 10 years [124]. Biological pest control is performed on 96.3% of this cultivated land area. Biocontrol, using an antagonist, represents a potentially attractive disease management approach to reduce the side effects of fungicides as environmental pollutants. Therefore, the main objectives of this study were to determine (a) the potential of different BCAs against P. capsici and P. parasitica in vitro and in vivo; (b) the effect of volatile and non-volatile antifungal metabolites in vitro; (c) the effect of different BCAs on the development of diseases caused by both plant pathogens in vivo; and (d) the differential expression of the genes involved in plant defence responses, CaBGLU, CaRGA1, CaBPR1, CaPTI1, and CaSAR8.2, during the onset of marked symptoms in plants inoculated with both pathogens.
2. Materials and Methods
2.1. Fungal Isolates
The following BCAs were selected in this study: Trichoderma aggressivum f. europaeum Samuels & W. Gams (TA) [125,126], T. longibrachiatum Rifai (TL) [126], Paecilomyces variotii Bainier (PAE) [127], and T. saturnisporum Hammil (TS) [72]. TS has been previously described as a BCA for P. parasitica and P. capsici [72,126], and was used as a reference to compare the efficacy of the fungal isolates TA, TL, and PAE tested in this study (Figure 1). All isolates were deposited in the Phytopathology laboratory of the Department of Agronomy, Universidad de Almería, (UAL), Spain.
Figure 1.
Fungal isolates used in this assay: (A) T. saturnisporum; (B) T. longibrachiatum; (C) T. aggressivum f. europaeum; (D) P. variotii.
Plants infected with P. parasitica and P. capsici were collected from pepper crops in the province of Almeria (Spain). Stem sections with active lesions were cut and tissue pieces from the boundaries between healthy and discoloured areas were disinfected with 2% NaOCl for 2 min and then abundantly washed with sterile distilled water. These fragments were dried on sterile paper and subsequently placed on potato dextrose agar (PDA, Cultimed Panreac EU). Once the isolates were obtained, pathogenicity tests were carried out on pepper plants (Capsicum annuum L. cv. Acorde) using the methods of Diánez et al. [72].
BCA isolates were grown on PDA for 5 or 10 days at 25–27 ± 2 °C under dark conditions and were maintained on PDA at 4 °C. Phytophthora parasitica and P. capsici were maintained on V8 agar.
2.2. Dual Culture Bioassays
TA, TS, TL, and PAE were screened for their antagonism in vitro against P. parasitica and P. capsici. The antagonism assay was performed on PDA in Petri dishes using the dual culture method [128]. Plugs of 0.5 cm of mycelia of all fungi were cut from the growing edge of 10-day-old cultures with active growth of each isolate. The plugs were placed at the ends of Petri dishes with a distance of 8 cm between the two fungi and antagonist–phytopathogen. The antagonistic fungus was placed in the Petri dish 24 h before the pathogen. All plates were sealed with Parafilm® and incubated in the dark at 25 °C until the controls reached the edge of the Petri dish. Radial fungal colony growth was measured daily. Results were transformed into percentages of mycelium growth inhibition (PIRM). These tests were carried out in quintuplicate.
2.3. Antifungal Volatile and Non-Volatile Metabolite Bioassay
The antifungal activity of volatile organic compounds (VOCs) of TA, TS, TL, and PAE against P. parasitica and P. capsici was assessed using the procedure described by Phoka et al. [97] and bi-compartment dishes. All fungi were grown in PDA medium for 5 days at 25 °C in the dark. A 0.5-cm-wide plug of each antagonist fungus was placed 0.5 cm from the edge of the plate in a compartment. Similarly, in the other compartment of the plate, the pathogen was placed as described above, 24 h later. The plates were sealed with 3 layers of parafilm and incubated at 25 °C in the dark for 5 days. The fungal diameter was measured and compared with control plates (without antagonist). The experiment was performed in quintuplicate and repeated twice.
To determine the antifungal activity of non-volatile organic compounds (N-VOCs) of TA, TS, TL, and PAE, Erlenmeyer flasks (500 mL) containing 100 mL of PDB medium (Cultimed Panreac EU) were inoculated with two 0.5-cm-wide plugs of each antagonistic fungus. The flasks were incubated without stirring at 25 °C in the dark for 7, 14, 21, and 30 days. Mycelia were harvested by filtration through two layers of cheesecloth and the supernatant was filtered through sterile Millipore membranes (pore size 0.22 μm) and collected in sterile tubes. Filtrates were then incorporated and mixed with the cooled PDA at 5, 10, or 15% (v:v) and immediately poured into 50 mm Petri dishes [129]. The plates without filtrate served as control. A mycelial disc of 5 mm diameter of P. parasitica and P. capsici was put in the centre of the Petri plates. The cultures were incubated at 25 °C for 7 days. The colony diameter was measured and the percentage inhibition of the radial growth was calculated. Each assay was performed in quintuplicate.
2.4. Effects of TA, TS, TL, and PAE Isolates on the Severity of Phytophthora Blight in Pepper
TA, TS, TL, and PAE isolates were tested for biocontrol of Phytophthora blight (P. capsici and P. parasitica) in pepper plants (Capsicum annuum L., cv. Largo de Reus). The experiment was performed in two phases, one phase in a nursery and another in a greenhouse. Two independent experiments were conducted using completely randomised block designs.
Seedling was performed according to the procedure described by Sanchez-Montesinos et al. [130]. Pepper seeds were sown in 96-cell, commercial peat mix-filled, nursery polystyrene planting trays (70 mL volume) and covered with vermiculite. Trays were relocated to a greenhouse and rinsed with sterile distilled water (control) or a 5 mL (TA, TS, TL, or PAE) spore suspension per cell at 105 spores per plant, after a 4-day period in a germination room (relative humidity (RH) = 95%; 25 °C). Two trays of seedlings for each treatment were cultivated under standard nursery culture conditions (18–28 °C; 75.4 ± 6.7% RH). After 45 days at the commercial nursery, 240 plants were transferred to pots (1 L capacity) containing peat moss, 40 plants of each antagonistic isolate, 40 control plants for each pathogen, and 40 plants for non-pathogen control. After transplanting, 50% of the plants were reinoculated with the same dose of the antagonist (R). After 7 days, all plants (except non-pathogen controls) were then inoculated with 5 mL of the zoospore suspension (104 zoospores·mL−1) using a sterile micropipette, as described by Diánez et al. [72]. Symptom severity was rated periodically and final disease severity index was estimated according to the following scale [72]: 1, healthy plant; 2, symptoms beginning; 3, moderate symptoms; 4, severely affected plant; and 5, dead plant (Figure 2).
Figure 2.
Disease severity scale for Phytophthora capsici; the same scale is used for P. parasitica. (1) Healthy plant; (2) symptoms beginning; (3) moderate symptoms; (4) severely affected plant; (5) dead plant.
2.5. Effect of Antagonists on the Chlorophyll Content of Peppers
Chlorophyll content from the fourth leaf was determined using a SPAD 502 Plus Chlorophyll Meter (Konica Minolta, Inc., Ramsey, NJ, United States). The SPAD values were converted to chlorophyll using the formula described by Ling et al. [131]. The experiment was carried out in triplicates, with 10 plants measured at 15 and 45 days after transplanting (DATs).
2.6. RNA Extraction and Real-Time Polymerase Chain Reaction (RT-PCR)
The differential expression of the genes CaBGLU (C. annuum β-1,3-glucanase), CaRGA1 (blight resistance protein), CaBPR1 (basic PR protein 1), CaPTI1 (ethylene responsive factor), and CaSAR8.2 (Systemic Acquired Resistance 8.2) was determined using real-time PCR for all the treatments when the plants showed symptoms at stage 2 (62–65 days after the first application of the BCAs and 7–10 days after pathogen inoculation) and, similarly, in healthy plants inoculated with different BCAs (without pathogen). Gene expression was compared with the controls without inoculation. Leaves of a similar developmental stage were collected, frozen in liquid nitrogen, and kept at −80 °C until processing.
Total RNA was extracted from samples of pepper leaves using a commercial RNA PureLink RNA Mini Kit (Invitrogen), following the manufacturer’s manual. The samples were reduced to a smaller size and homogenised prior to the extraction with FastPrep-24 5G (MP Biomedical) for 40 s at a speed of 6 m/s. The quality and concentration of RNA was quantified by Nanodrop 2000 (Thermo Fisher Scientific, Waltham, MA, USA). In all cases, RNA concentrations were higher than 100 ng/µL and RNA extracts were stored at −20 °C. The high-capacity cDNA Reverse Transcription Kit (Applied Biosystems, by Thermo Fisher Scientific) was used to obtain cDNA from 1 μg of RNA. The cDNA was used as a template for the subsequent RT-PCR.
Quantitative RT-PCR was performed on a MyGo Pro® RealTime PCR System using the SYBR Green fluorophore with the specific primers shown in Table 1. The SYBR Green reactions were performed in a 20 μL reaction mix comprising 1.5 ng of DNA, 10 μL of the SensiFAST SYBR No-ROX Kit (Bioline), and 2 μL of each of the primers (2 μM). The ACT gene was used as the housekeeping gene for data normalisation. In all reactions, amplifications were carried out under the following conditions: an initial hold step of 95 °C for 5 min and 45 PCR cycles of 95 °C for 15 s and 60 °C for 1 min. All Ct (cycle threshold) values were considered positive in the 18–35 range. Double delta Ct (ΔΔCT) analysis was used for determining relative expression [132] and the measurement of each gene was normalised with respect to the ACT gene. For each pair of primers, the melting curve was analysed to evaluate the specificity of the amplification, with high specificity in all cases. The visualisation of a single peak in the melting curve indicated a single specific fragment, the absence of primer dimers, and the lack of nonspecific products. For every experiment, mean values of six replicates are given for every concentration of samples tested, and their standard deviations are represented as error bars in figures.
Table 1.
PCR primers used in SYBR Green assays.
2.7. Statistical Analysis
The experimental results are presented as mean values (±standard deviation) for the different replicates. Mean separation was carried out using Fisher’s least significant difference (LSD) test. The data were tested by one-way analysis of variance (ANOVA) or Student’s t-test, with significance defined as p-values less than 0.05 (p < 0.05). Statgraphics Centurion 18 software was utilised for statistical analysis.
3. Results
3.1. Dual Culture Bioassays
All isolates showed high antagonistic activity against both Phytophthora species. P. variotii inhibition peaked at 83 and 87% for P. parasitica and P. capsici, respectively, at 7 days of incubation. The BCAs TA, TS, and TL showed similar high antagonistic activity values of approximately 88 and 82% for P. parasitica and P. capsici, respectively, and their activity peaked after 3 days of incubation (Figure 3).
Figure 3.
Mycelial growth of P. capsici (Pc) (A) and P. parasitica (Pp) (B) against T. aggressivum f. europaeum (TA), P. variotii (PAE), T. longibrachiatum (TL), and T. saturnisporum (TS), which peaked at 17 and 27 days, respectively.
3.2. Antifungal Volatile and Non-Volatile Metabolite Bioassay
The in vitro antifungal activity of VOCs (Figure 4) and N-VOCs (Table 2) produced by the isolates of TA, TS, TL, and PAE was tested against P. parasitica and P. capsici. The VOCs of TL and TA showed the highest percentages of growth inhibition for both plant pathogens of all isolates tested in this study, reaching approximately 50 and 20% inhibition, respectively. Conversely, the VOCs of PAE showed a weak growth inhibition effect against P. parasitica (5.43%) and no effect against P. capsici. Similarly, P. capsici growth was not affected by the VOCs of TS.
Figure 4.
Colony diameter (mm) and mycelial inhibition (%) of P. parasitica (PP) and P. capsici (PC) by VOCs of T. aggressivum f. europaeum (TA), P. variotii (PAE), T. longibrachiatum (TL), and T. saturnisporum (TS). Mean values (±standard deviation) followed by different letters (line) indicate significant differences (p < 0.05) using the least significant difference (LSD) test.
Table 2.
Mycelial growth of P. parasitica and P. capsici in PDA medium supplemented with 5, 10, and 15% microfiltered extract of TA, TL, TS, and PAE at different incubation times (7, 15, 21 and 30 days) in the dark and at 25 °C.
In turn, all N-VOCs showed a slight growth inhibition of both phytopathogens (Table 2). Unexpectedly, the N-VOCs presented an inhibition range of PC and PP lower than 20 and 15%, respectively, as well as lower PAE and higher TL growth inhibition values.
3.3. Effects of TA, TS, TL, and PAE Isolates on the Severity of Phytophthora Blight in Pepper
At the end of the assay, the plants not treated with the pathogens (T0) were asymptomatic. Plants inoculated with P. capsici and P. parasitica showed a mean disease rating of 5 and 4.2, respectively, with 100% incidence in both cases.
The in-plant antagonistic effectiveness of the BCA test strains against P. parasitica was higher than that against P. capsici. In both cases, nevertheless, the percentage of plants without symptoms was higher in plants reinoculated with the BCAs. No plants died when treated with PAE (considering a disease rating of 4 and 5), and plants treated with TL and with no symptoms reached a maximum disease rating of 2 (Figure 5).
Figure 5.
Effectiveness of BCAs in controlling disease caused by Phytophthora at end of assay (60 DATs): (A) distribution of plants in the greenhouse; (B) state of controls plants and plants treated with (C) T. longibrachiatum (TL), (D) T. aggressivum f. europaeum (TA), (E) T. saturnisporum (TS), and (F) P. variotii (PAE).
Based on the results outlined in Table 3, the treatments with TL, PAE, and TA substantially reduced the severity of the disease caused by P. capsici, with 76, 70, and 54%, respectively, over untreated control plants (100% of mortality). Similarly, all reinoculation treatments provided better results, with TL showing the strongest antagonistic effect, reaching 78% disease severity reduction.
Table 3.
Phytophthora parasitica and P. capsici disease severity in pepper inoculated with TA, TS, TL, or PAE (105 spores per plant) in two experiments in greenhouse conditions in which plants were inoculated with antagonist before the pathogen and before/after (reinoculated, R). All plants, except for controls (T0), were then inoculated with 5 mL of zoospore suspension (104 zoospores·mL−1). Disease severity was assessed on a 1–5 scale, where 1 indicated free of infection (plants without symptoms) and 5 indicated dead plant.
3.4. Effect of Antagonists on the Chlorophyll Content of Peppers
The chlorophyll content of plants infected with both pathogens and non-pathogens did not differ between treatments at 15 and 45 DATs. However, at 45 days, the plants inoculated with P. capsici, P. parasitica, and Trichoderma longibrachiatum showed a substantial increase in chlorophyll content, which reached 67 and 80% in both treatments (TL and TLR) for P. capsici and 56% for P. parasitica (TLR) in relation to the control (T0) (data not shown).
3.5. Molecular Responses of Pepper Leaves
Figure 6 shows the results from the analysis of the relative expression of the defence-related genes CaBGLU, CaRGA1, CaBPR1, CaPTI1, and CaSAR8.2 at disease onset. This analysis was performed in leaves for all treatments with BCAs, comparing the results of these pepper plants with and without pathogen inoculation when they started showing symptoms (the samples were collected from plants with a disease severity rating of 2).
Figure 6.
Analysis of the relative expression of defence-related genes CaBGLU, CaRGA1, CaBPR1, CaPTI1, and CaSAR8.2. Each bar represents relative gene expression for all conditions tested. Expressions of genes were normalised with respect to the ACT gene. Values were calculated following three replications, and standard deviations are shown.
Considering the levels of each gene in relation to the levels of constitutively expressed CaActin, we observed that the expression levels of CaBGLU transcripts were not increased in plants treated with P. parasitica in any treatment tested in this study. However, inoculation with P. capsici produced the highest increase in the level of expression (two-fold), which decreased again after applying BCAs. Similarly, the CaBGLU gene was induced at low levels when applying BCAs only, except for TL, which increased the expression of this gene six-fold, and for TA and TAR, which doubled the expression of this gene.
The expression of the gene CaRGA1 was moderately induced by BCAs, ranging from 1.68 to 4.69 times. These increased expression levels were maintained when incubating the plants with the pathogens. Strong induction of the CaSAR8.2 gene also was found in pepper leaves treated with BCAs. For P. parasitica, the expression increased between 1.2 and four times, and the values were even higher upon reinoculation with BCAs. Expression was activated not only when inoculating with P. capsici, but when inoculating with BCAs. The application of BCAs alone showed a moderate level of expression activation in some cases, such as TL and TAR. The expression of the genes CaBPR1 and CaPI1 did not increase in any treatment.
4. Discussion
The importance of the biological activity of microorganisms close to plant roots has been highlighted in numerous studies on the biological control of oomycetes [137]. In soils rich in microorganisms, their competition for space and nutrients is intense, with a high production of numerous compounds and enzymes that limit the growth and development of plant pathogens, thus reducing the incidence of diseases. Moreover, many microorganisms stimulate plant growth or induce plant resistance to pathogens.
The control of diseases caused by oomycetes is particularly complex. Most of them produce effectors, which abolish or reduce plant defence responses against their attacks, and metabolites and enzymes, which degrade plant material, facilitating their penetration [138]. Numerous species of the genera Trichoderma and Paecilomyces have been reported to have fungicidal capacity against Phytophthora [72,139,140,141,142,143,144,145,146,147]. In the present study, the P. capsici and P. parasitica growth suppression effect of T. aggressivum f. europaeum, T. longibrachiatum, T. saturnisporum, and P. variotii was assessed in peppers.
In both in vitro and in vivo assays, the two plant pathogens showed differences in their relationship with BCAs. High antifungal activity (>80%) was observed in dual in vitro assays in PDA medium, with the plant pathogens reaching the maximum growth at 3 and 7 days of incubation for Trichoderma and Paecilomyces isolates, respectively. The three Trichoderma species completely overgrew the colony of the pathogen, showing hyperparasitism. Previous studies have shown the antifungal activity of these isolates against other plant pathogens, such as Botrytis cinerea, Sclerotinia sclerotiorum, and Mycosphaerella melonis, with a high efficacy [125,139]. These inhibition results are also very similar to those of Diánez et al. [72] when analysing Trichoderma saturnisporum. In turn, Ezziyyani et al. [146] found that T. harzianum provided inhibition values higher than 80% against P. capsici. Considering the variability of the protocols used in dual in vitro assays regarding the type and thickness of the solid culture medium in Petri dishes, the temperature, and the presence or absence of light, these results should be interpreted with caution because they are highly variable and often lack correlation between in vitro and in vivo conditions. Furthermore, the in vivo results depend on numerous factors, such as BCA dose, application time and method, and crop.
The Trichoderma species showed antifungal activity against Phytophthora. Nevertheless, the activity of N-VOCs and VOCs of Paecilomyces was very low or null. Volatile (VOCs) and non-volatile (N-VOCs) secondary metabolites of the Trichoderma and Paecilomyces species have different biological activities, such as biostimulation or biocontrol [147,148,149,150,151]. Li et al. [149] described 390 non-volatile components of 20 Trichoderma species, including T. saturnisporum and T. longibrachiatum, with antibacterial and antifungal capacity. In turn, Bae et al. [150] identified different non-volatile compounds produced by different Trichoderma species which showed the strongest inhibitory activities against Phytophthora isolates. Dai et al. [151] described 223 secondary metabolites and their biological activities isolated from different Paecilomyces species. Among them, only the compound farinomalein, isolated from P. farinosus, was a potent inhibitor of the plant pathogen Phytophthora sojae. Moreno et al. [152] did not assess high growth inhibition values of plant pathogens such as F. solani and M. melonis induced by N-VOCs and VOCs of P. variotii.
In our study, we found a high control of pepper plant diseases caused by P. parasitica and P capsici. The success of these results is derived mainly from inoculating BCAs in the seedbed phase. Consequently, when the plants were transplanted to the greenhouse, their roots were already colonised by BCAs and therefore “prepared” for a possible attack by phytopathogens, as clearly shown by the inability of reinoculation to significantly reduce disease severity, except for T. saturnisporum. In this case, reinoculation reduced disease severity by 57 and 70% for P. parasitica and P. capsici, respectively.
It has been reported that the addition of different species of Trichoderma in a plant’s rhizosphere induces resistance due to the rise in the amounts of defensive metabolites as well as enzymes, which act as elicitors [153]. In contrast to this assay, most studies aimed at identifying genes related to plant defence mechanisms against different pathogens are usually performed in the first hours after contact with elicitors, whether they are plant pathogens or beneficial microorganisms. We observed an increase in the relative expression of some plant defence-related genes, such as CaBGLU, CaRGA1 and CaSAR8.2, when applying BCAs, except in the TS treatment. This exception could be directly related to the high disease expression shown despite the application of T. saturnisporum, which requires plant reinoculation for improved control. However, this hypothesis was not confirmed when applying BCAs together with both phytopathogens. Jung and Hwang [154] showed that the accumulation of CaBGLU mRNA on the stems of peppers infected with P. capsici was greatly reduced between 48 and 96 h, possibly due to deterioration of the infected stems. They concluded that pepper basic b-1,3-glucanase may mediate a part of the defence responses to pathogen infections. Conversely, the induction of defence-related genes, such as CaPR1 and CaBGLU, is essential for SAR in pepper plants [155,156]. Additionally, some researchers have reported that the level and onset of β-glucanase expression is often positively correlated with the degree of resistance to the pathogen [156]. Accordingly, Jung and Hwang [154] observed that CaBGLU mRNA increased in the first stage of infection to similar levels in both compatible and incompatible interactions with P. capsici, but at later times, the gene had higher expression in the incompatible interaction. In our study, the expression of these genes was not increased in plants inoculated with P. parasitica, even though plants co-inoculated with BCAs showed some degree of resistance against disease and did not die. For P. capsici, the relative expression of the gene CaBGLU in leaves was low, but no correlation with a defence response was found since the maximum disease severity was reached in all control plants without BCAs, which showed a 2-fold expression induction.
A high number of disease resistance genes are induced by P. capsici invasion, such as CaRGA1 [157]. The study of the expression of RGA genes under pathogen attack would facilitate the determination of whether they play an active role in resistance or if they are merely linked to resistance genes [157]. Our results showed a low induction of the expression of this gene in all treatments, which reached higher values when BCAs were applied without the pathogen, except for TS. The application of P. parasitica did not increase the relative expression of this gene.
Silvar et al. [158] observed a strong and rapid induction of the CaBPR1 gene in an incompatible interaction of pepper plants with P. capsici. Similarly, overexpressing this gene in tobacco plants increased tolerance to P. nicotianae and to the bacterial pathogens Ralstonia solanacearum and Pseudomonas syringae pv. tabaci [159]. This gene apparently plays a key role in the ability of resistant pepper cultivars to restrict pathogen colonisation, which is conversely weak in susceptible genotypes. In our study, the expression of this gene did not increase under the conditions of this assay, corroborating the findings of Sarowar et al. [159]. The expression of the gene CaPTI1 did not change either, in contrast to the results reported by Jin et al. [98], who highlighted the high expression levels of the gene CaPTI1 after inoculation with P. capsici, which were higher in stems than in leaves.
The SAR8.2 gene is a gene that controls plant resistance to P. nicotianae [160]. Lee and Hook [135] suggested that CaSAR8.2 functions as a molecular marker gene for various biotic and abiotic stresses in pepper plants. The relative expression results may be directly related to the resistance response observed for both plant pathogens tested in this study, further highlighting that BCA reinoculation decreases disease incidence and severity, and in turn increases the expression of the CaSAR8.2 gene.
The expression of these genes does not seem to be linked to the ability to develop symptoms, except for the gene CaSAR8.2. The results of these plants must be compared with those of plants without any symptoms and at times near inoculation as well. In our study, we were unable to clearly identify the genes involved in improving plant resistance. Genes involved in the early response of plants with resistant genotypes, such as CaBPR1, showed no changes in expression. However, the relative expression levels of genes involved in SAR responses were increased. In any event, the high variability of the results found in different samples or replicates makes it difficult to interpret the results. Therefore, further studies are needed to clarify the role that these genes play in reducing disease severity.
Biological control is presented as an ecological and healthy alternative to chemical control. As commented above, numerous studies have shown the different mechanisms of action that microorganisms use to control the growth and multiplication of the plant pathogens and pests that affect crops. This scientific development contrasts with the reality in the field. The preventive nature of this type of control, possible changes in crop management, and new pest and disease problems resulting from climate change, make it difficult to broadly implement such solutions. The withdrawal of numerous commonly used phytosanitary active ingredients has forced production systems to search for and develop new biological control agents. In addition, farmers and technicians must change their mindset for biological control to work. The use of BCAs from the seedbed, which reduces the inoculum levels of the pathogen in crops, combined with the use of plant varieties with some degree of resistance to some diseases and reduced doses of fungicide could provide high levels of disease control.
5. Conclusions
We are the first to describe P. parasitica and P. capsici control using T. aggressivum f. europaeum and Paecilomyces variotii. In addition, a marine isolate, T. longibrachiatum, showed a high capacity to suppress disease expression. BCA reinoculation increased plant survival and the percentage of plants without symptoms. Similarly, applying beneficial microorganisms moderately activated genes involved in the defence responses in pepper plants.
Author Contributions
Conceptualisation, M.S. and F.D.; methodology, B.S.-M., J.A.G.-C. and B.E.G.; software, B.E.G. and A.M.-G.; validation, M.S., F.D., B.E.G., J.A.G.-C. and F.J.G.; formal analysis, V.H., B.E.G. and B.S.-M.; investigation, M.S., F.D., B.S.-M., A.M.-G. and B.E.G.; resources, M.S., F.D. and F.J.G.; data curation, M.S. and F.D.; writing—original draft preparation, M.S. and F.D.; writing—review and editing, B.E.G., V.H., A.M.-G., F.J.G. and B.S.-M.; visualisation, F.J.G.; supervision, J.A.G.-C. All authors have read and agreed to the published version of the manuscript.
Funding
This study received no external funding.
Institutional Review Board Statement
Not applicable.
Informed Consent Statement
Not applicable.
Data Availability Statement
Not applicable.
Acknowledgments
This study benefited from the input of project UAL-2020-AGR-A1949 and was supported by the I+D+I Projects Andalucia Feder Operational Program 2014–2020.
Conflicts of Interest
The authors declare no conflict of interest.
References
- Beakes, G.; Sekimoto, S. The evolutionary phylogeny of Oomycetes–insights gained from studies of holocarpic parasites of algae and invertebrates. In Oomycete Genetics and Genomics: Diversity, Interactions, and Research Tools; Lamour, K., Kamoun, S., Eds.; Wiley: New York, NY, USA, 2009; pp. 1–24. [Google Scholar] [CrossRef]
- Jayawardena, R.S.; Hyde, K.D.; Chen, Y.J.; Stadler, M.; Wang, Y. One stop shop IV: Taxonomic update with molecular phylogeny for important phytopathogenic genera. Fungal Divers. 2020, 103, 87–218. [Google Scholar] [CrossRef]
- Mitchell, D.J. Relationships of inoculum levels of several soilborne species of Phytophthora and Pythium to infection of severalhosts. Phytopathology 1978, 68, 1754–1759. [Google Scholar] [CrossRef]
- Bala, K.; Robideau, G.P.; Lévesque, C.A.; de Cock, A.; Abad, Z.; Lodhi, A.; ShahzadS, S.; Ghaffar, A.; Coffey, M. Persoonia—Molecular Phylogeny and Evolution of Fungi. Fungal Planet 2010, 24, 136–137. [Google Scholar] [CrossRef]
- Ho, H.H. The taxonomy and biology of Phytophthora and Pythium. J. Bacteriol. Mycol. 2018, 6, 40–45. [Google Scholar] [CrossRef]
- Tkaczyk, M. Phytopythium: Origin, differences and meaning in modern plant pathology. Folia For. Pol. A 2020, 62, 227–232. [Google Scholar] [CrossRef]
- de Cock, A.W.A.M.; Lodhi, A.M.; Rintoul, T.L.; Bala, K.; Robideau, G.P.; Abad, G.Z.; Coffey, M.D.; Shahzad, S.; Lévesque, C.A. Phytopythium: Molecular phylogeny and systematics. Persoonia 2015, 34, 25–39. [Google Scholar] [CrossRef]
- Brasier, C.M.; Cooke, D.E.; Duncan, J.M. Origin of a new Phytophthora pathogen through interspecific hybridization. Proc. Natl. Acad. Sci. USA 1999, 96, 5878–5883. [Google Scholar] [CrossRef] [PubMed]
- Goheen, E.M.; Frankel, S.J. Phytophthoras in forests and natural ecosystems. In Proceedings of the Fourth Meeting of the International Union of Forest Research Organizations (IUFRO) Working Party S07.02.09, Monterey, CA, USA, 27 September 2021. [Google Scholar]
- Martin, F.N.; Abad, Z.G.; Balci, Y.; Ivors, K. Identification and detection of Phytophthora: Reviewing our progress, identifying our needs. Plant Dis. 2012, 96, 1080–1103. [Google Scholar] [CrossRef]
- Božik, M.; Mrázková, M.; Novotná, K.; Klouček, P.; Černý, K. MALDI-TOF MS as a method for rapid identification of Phytophthora de Bary, 1876. Peer. J. 2021, 9, e11662. [Google Scholar] [CrossRef]
- Yang, X.; Tyler, B.M.; Hong, C. An expanded phylogeny for the genus Phytophthora. IMA Fungus 2017, 8, 355–384. [Google Scholar] [CrossRef]
- Blair, J.E.; Coffey, M.D.; Park, S.Y.; Geiser, D.M.; Kang, S. A multi-locus phylogeny for Phytophthora utilizing markers derived from complete genome sequences. Fungal Genet. Biol. 2008, 45, 266–277. [Google Scholar] [CrossRef] [PubMed]
- Goss, E.M.; Cardenas, M.E.; Myers, K. The plant pathogen Phytophthora andina emerged via hybridization of an unknown Phytophthora species and the Irish potato famine pathogen, P. infestans. PLoS ONE 2011, 6, e24543. [Google Scholar] [CrossRef] [PubMed]
- Brasier, C.; Scanu, B.; Cooke, D.; Jung, T. Phytophthora: An ancient, historic, biologically and structurally cohesive and evolutionarily successful generic concept in need of preservation. IMA Fungus 2022, 13, 12. [Google Scholar] [CrossRef] [PubMed]
- Yang, X.; Richardson, P.A.; Hong, C. Phytophthora × stagnum notho sp. Nov., a new hybrid from irrigation reservoirs at ornamental plant nurseries in Virginia. PLoS ONE 2014, 9, e103450. [Google Scholar] [CrossRef]
- Brasier, C.M.; Kirk, S.A.; Delcan, J.; Cooke, D.E.L.; Jung, T.; Manin’t Veld, W.A. Phytophthora alni sp. nov. and its variants: Designation of emerging heteroploid hybrid pathogens spreading on Alnus trees. Mycol. Res. 2004, 108, 1172–1184. [Google Scholar] [CrossRef] [PubMed]
- Burgess, T.I. Molecular characterization of natural hybrids formed between five related indigenous clade 6 Phytophthora species. PLoS ONE 2015, 10, e0134225. [Google Scholar] [CrossRef]
- Van Poucke, K.; Haegeman, A.; Goedefroit, T.; Ruttink, T.; Heungens, K. Unravelling hybridization in Phytophthora using phylogenomics and genome size estimation. IMA Fungus 2021, 12, 1–24. [Google Scholar] [CrossRef]
- Rodríguez-Molina, M.C.; Morales-Rodríguez, M.C.; Palo Osorio, C.; Duarte Maya, M.S.; Picón-Toro, J. Phytophthora nicotianae, the causal agent of root and crown rot (Tristeza disease) of red pepper in La Vera region (Cáceres, Spain). Span. J. Agri. Res. 2010, 8, 770–774. [Google Scholar] [CrossRef]
- Lacasa, C.M.; Martínez, V.; Hernández, A.; Serrano-Pérez, P.; Larregla, S. Survival reduction of Phytophthora capsici oospores and P. nicotianae chlamydospores with Brassica green manures combined with solarization. Sci. Hortic. 2015, 197, 607–618. [Google Scholar] [CrossRef]
- Alcantara, T.P.; Bosland, P.W. An inexpensive disease screening technique for foliar blight of chile pepper seedlings. HortScience 1994, 29, 1182–1183. [Google Scholar] [CrossRef]
- Lamour, K.H.; Stam, R.; Jupe, J. The oomycete broad-host-range pathogen Phytophthora capsici. Mol. Plant Pathol. 2012, 13, 329–337. [Google Scholar] [CrossRef] [PubMed]
- Liu, X.; Zhou, Y.; Li, L. Infection of Phytophthora capsici on pepper-Models and affecting factors. Front. Agri. China 2008, 2, 66–71. [Google Scholar] [CrossRef]
- Café-Filho, A.C.; Duniway, J.M. Effect of location of drip irrigation emitters and position of Phytophthora capsici infections in roots on Phytophthora root rot of pepper. Phytopathology 1996, 86, 1364–1369. [Google Scholar]
- Hausbeck, M.K.; Lamour, K.H. Phytophthora capsici on vegetable crops: Research progress and management challenges. Plant Dis. 2004, 88, 1292–1303. [Google Scholar] [CrossRef]
- European Commission. Regulation (EC) no. 1005/2009 of the European Parliament and of the council of 16 September 2009 on substances that deplete the ozone layer (recast). Off. J. Eur. Union 2009, 286, 1–30. [Google Scholar]
- Ploetz, R.C.; Heine, G.; Haynes, J.L.; Watson, M. Investigating biological attributes that may contribute to Phytophthora capsici importance as a vegetable pathogen in Florida. Ann. Appl. Biol. 2002, 140, 61–67. [Google Scholar] [CrossRef]
- Parra, G.; Ristaino, J.B. Resistance to mefenoxam and metalaxyl among field isolates of Phytophthora capsici causing Phytophthora blight of bell pepper. Plant Dis. 2001, 85, 1069–1075. [Google Scholar] [CrossRef]
- Gisbert, C.; Sánchez-Torres, P.; Raigón, M.D.; Nuez, F. Phytophthora capsici resistance evaluation in pepper hybrids: Agronomic performance and fruit quality of pepper grafted plants. J. Agric. Food Inf. 2010, 8, 116–121. [Google Scholar] [CrossRef]
- Ros, C.; Lacasa, C.M.; Martínez, V.; Bielza, P.; Lacasa, A. Response of pepper rootstocks to co-infection of Meloidogyne incognita and Phytophthora spp. Eur. J. Hortic. Sci. 2014, 79, 22–28. [Google Scholar]
- López-Marín, J.; Galvez, A.; Porras, I.; Brotons-Martínez, J.M. Pepper grafting (Capsicum annuum): Benefits and profitability. ITEA 2016, 112, 127–146. [Google Scholar]
- Guigón-López, C. Differential development of wilt and stem rot diseases in grafted bell pepper (Capsicum annuum, L.). Eur. J. Plant Pathol. 2019, 154, 347–357. [Google Scholar] [CrossRef]
- Kousik, C.S.; Ikerd, J.L.; Hassell, R. Grafting onto resistant rootstocks for managing Phytophthora crown rot of peppers. Acta Hort. 2021, 13, 163–168. [Google Scholar] [CrossRef]
- Guerrero, M.M.; Ros, C.; Guirao, P.; Martínez, M.A.; Martínez, M.C.; Barceló, N. Biofumigation plus solarisation efficacy for soil disinfestation in sweet pepper greenhouses in the Southeast of Spain. Acta Hort. 2005, 698, 293–297. [Google Scholar] [CrossRef]
- Guerrero, M.M.; Ros, C.; Lacasa, C.; Martínez, V.; Lacasa, A.; Fernández, P. Effect of biosolarization using pellets of Brassica carinata on soilborne pathogens in protected pepper crops. Acta Hort. 2010, 883, 337–344. [Google Scholar] [CrossRef]
- Butler, D.M.; Kokalis-Burelle, N.; Muramoto, J.; McCollum, T.G.; Rosskopf, E.N. Impact of anaerobic soil disinfestation combined with soil solarization on plant-parasitic nematodes and introduced inoculum of soilborne plant pathogens in raised-bed vegetable production. Crop. Prot. 2012, 39, 33–40. [Google Scholar] [CrossRef]
- Núñez-Zofío, M.; Larregla, S.; Garbisu, C. Repeated biodisinfection controls the incidence of Phytophthora root and crown rot of pepper while improving soil quality. Span. J. Agric. Res. 2012, 10, 794–805. [Google Scholar] [CrossRef]
- Larregla, S.; Núñez-Zofío, M.; Fernández-Molina, P.; Lacasa-Martinez, C.M.; Guerrero-Díaz, M.M. Reduction of Phytophthora capsici oospores viability by gases released during soil biosolarization of protected pepper crops in southeastern Spain. Acta Hort. 2014, 1044, 113–118. [Google Scholar] [CrossRef]
- Rodríguez-Molina, M.C.; Serrano-Pérez, P.; Palo, C. Effect of biofumigation with brassica pellets combined with Brassicaceae cover crops and plastic cover on the survival and infectivity of inoculum of Phytophthora nicotianae Breda de Haan. Pest Manag. Sci. 2016, 72, 1295–1301. [Google Scholar] [CrossRef]
- Gandariasbeitia, M.; Ojinaga, M.; Orbegozo, E.; Mendarte, S.; Larregla, S. Winter biodisinfestation with Brassica green manure is a promising management strategy for Phytophthora capsici control of protected pepper crops in humid temperate climate regions of northern Spain. Span. J. Agric. Res. 2019, 17, 1005. [Google Scholar] [CrossRef]
- Larregla, S.; Gandariasbeitia, M.; Ojinaga, M.; Guerrero, M.D.M.; Ortiz-Barredo, A. Gases Released During Soil Biodisinfestation of Pepper Greenhouses Reduce Survival of Phytophthora capsici Oospores in Northern Spain. Front. Sustain. Food Syst. 2021, 5, 663–915. [Google Scholar] [CrossRef]
- Guerrero, M.D.M.; Lacasa, C.M.; Martínez, V.; Monserrat, A.; Larregla, S. Low Temperature Biodisinfection Effectiveness for Phytophthora capsici Control of Protected Sweet Pepper Crops in the Southeast of Spain. Front. Sustain. Food Syst. 2021, 5, 659290. [Google Scholar] [CrossRef]
- Babadoost, M.; Pavón, C. Survival of Oospores of Phytophthora capsici in Soil. Plant Dis. 2013, 97, 1478–1483. [Google Scholar] [CrossRef]
- Cheng, H.; Zhang, D.; Ren, L.; Wang, Q.; Cao, A. Bio-activation of soil with beneficial microbes after soil fumigation reduces soil-borne pathogens and increases tomato yield. Environ. Pollut. 2021, 283, 117–160. [Google Scholar] [CrossRef] [PubMed]
- Lorito, M.; Farkas, V.; Rebuffat, S.; Bodo, B.; Kubicek, C.P. Cell wall synthesis is a major target of mycoparasitic antagonism by Trichoderma harzianum. J. Bacteriol. 1996, 178, 6382–6385. [Google Scholar] [CrossRef] [PubMed]
- Santos, M.; Diánez, F. Los antagonistas microbianos en el manejo de micosis de la parte aérea de la planta. In Organismos Para el Control de Patógenos en los Cultivos Protegidos. Prácticas Culturales Para una Agricultura Sostenible, 2nd ed.; Tello, J.C., Camacho, F., Eds.; Fundación Cajamar: Almería, España, 2010; pp. 523–528. [Google Scholar]
- Wang, Q.; Ma, Y.; Wang, G.; Gu, Z.; Sun, D.; Andyz, X.; Chang, Z. Integration of biofumigation with antagonistic microorganism can control Phytophthora blight of pepper plants by regulating soil bacterial community structure. Eur. J. Soil Biol. 2014, 61, 58–67. [Google Scholar] [CrossRef]
- Galletti, S.; Sala, E.; Leoni, O.; Burzi, P.L.; Cerato, C. Trichoderma spp. tolerance to Brassica carinata seed meal for a combined use in biofumigation. Biol. Cont. 2008, 45, 319–327. [Google Scholar] [CrossRef]
- Joo, G.J. Production of an anti-fungal substance for biological control of Phytophthora capsici causing phytophthora blight in red-peppers by Streptomyces halstedii. Biotechnol. Lett. 2005, 27, 201–205. [Google Scholar] [CrossRef]
- Nguyen, X.H.; Naing, K.W.; Lee, Y.S.; Kim, Y.H.; Moon, J.H.; Kim, K.Y. Antagonism of antifungal metabolites from Streptomyces griseus H7602 against Phytophthora capsici. J. Basic Microbiol. 2015, 5, 45–53. [Google Scholar] [CrossRef]
- Nguyen, X.H.; Naing, K.W.; Lee, Y.S.; Tindwa, H.; Lee, G.H.; Jeong, B.K.; Kim, K.Y. Biocontrol potential of Streptomyces griseus H7602 against root rot disease (Phytophthora capsici) in pepper. Plant Pathol. J. 2012, 28, 282–289. [Google Scholar] [CrossRef]
- Sakineh, A.; Ayme, S.; Akram, S.; Naser, S. Streptomyces strains modulate dynamics of soil bacterial communities and their efficacy in disease suppression caused by Phytophthora capsici. Sci. Rep. 2021, 11, 9317. [Google Scholar] [CrossRef]
- Trinidad-Cruz, J.R.; Rincón-Enríquez, G.; Evangelista-Martínez, Z.; Quiñones-Aguilar, E.E. Biorational control of Phytophthora capsici in pepper plants using Streptomyces spp. Rev. Chapingo Ser. Hort. 2021, 27, 85–99. [Google Scholar] [CrossRef]
- Chen, Y.Y.; Chen, P.C.; Tsay, T.T. The biocontrol efficacy and antibiotic activity of Streptomyces plicatus on the oomycete Phytophthora capsici. Biol. Cont. 2016, 98, 34–42. [Google Scholar] [CrossRef]
- Yang, Y.; Zhang, S.W.; Li, K.T. Antagonistic activity and mechanism of an isolated Streptomyces corchorusii stain AUH-1 against phytopathogenic fungi. World J. Microbiol. Biotechnol. 2019, 35, 145. [Google Scholar] [CrossRef] [PubMed]
- Abbasi, S.; Safaie, N.; Sadeghi, A.; Shamsbakhsh, M. Tissue-specific synergistic bio-priming of pepper by two Streptomyces species against Phytophthora capsici. PLoS ONE 2020, 15, 230–531. [Google Scholar] [CrossRef]
- Sid, A.; Ezziyyani, M.; Egea-Gilabert, C.; Candela, M.E. Selecting bacterial strains for use in the biocontrol of diseases caused by Phytophthora capsici and Alternaria alternata in sweet pepper plants. Biol. Plant 2003, 47, 569–574. [Google Scholar] [CrossRef]
- Jiang, Z.; Guo, Y.; Li, S.; Qi, H.; Guo, J. Evaluation of biocontrol efficiency of different Bacillus preparations and field application methods against Phytophthora blight of bell pepper. Biol Cont. 2006, 36, 216–223. [Google Scholar] [CrossRef]
- Zhang, S.; White, T.L.; Martinez, M.C.; Mcinroy, J.A.; Kloepper, J.W.; Klassen, W. Evaluation of plant growth-promoting rhizobacteria for control of Phytophthora blight on squash under greenhouse conditions. Biol Cont. 2010, 53, 129–135. [Google Scholar] [CrossRef]
- Akgül, D.S.; Mirik, M. Biocontrol of Phytophthora capsici on pepper plants by Bacillus megaterium strains. J. Plant Pathol. 2008, 90, 29–34. [Google Scholar] [CrossRef]
- Lim, J.H.; Sang, D.K. Biocontrol of Phytophthora blight of red pepper caused by Phytophthora capsici using Bacillus subtilis AH18 and B. licheniformis K11 formulations. J. Korean Soc. Appl. Biol. Chem. 2010, 53, 766–773. [Google Scholar] [CrossRef]
- Yau, J.A.; Diánez, F.; Marín, F.; Carretero, C.; Santos, M. Screening and evaluation of potential biocontrol fungi and bacteria foliar endophytes against Phytophthora capsici and Phytophthora parasitica on pepper. J. Food Agric. Environ. 2013, 11, 490–495. [Google Scholar]
- Li, Y.; Feng, X.; Wang, X.; Zheng, L.; Liu, H. Inhibitory effects of Bacillus licheniformis BL06 on Phytophthora capsici in pepper by multiple modes of action. Biol. Cont. 2020, 144, 104–210. [Google Scholar] [CrossRef]
- Bhusal, B.; Mmbaga, M.T. Biological control of Phytophthora blight and growth promotion in sweet pepper by Bacillus species. Biol. Cont. 2020, 150, 104–373. [Google Scholar] [CrossRef]
- Naing, K.W.; Anees, M.; Nguyen, X.H.; Lee, Y.S.; Jeon, S.W.; Kim, S.J.; Kim, M.H.; Kim, K.Y. Biocontrol of late blight disease (Phytophthora capsici) of pepper and the plant growth promotion by Paenibacillus ehimensis KWN38. J. Phytopathol. 2014, 162, 367–376. [Google Scholar] [CrossRef]
- Mei, X.L.; Zhao, Q.Y.; Tan, S.Y.; Shen, B.; Shen, Q.R. Screening, identification, and biocontrol effect of antagonistic bacteria against Phytophthora capsici. Chin. J. Appl. Ecol. 2010, 21, 2652–2658. [Google Scholar]
- Gilardi, G.; Vasileiadou, A.; Garibaldi, A.; Gullino, M.L. Biocontrol agents and resistance inducers reduce Phytophthora crown rot (Phytophthora capsici) of sweet pepper in closed soilless culture. Phytopathol. Mediterr. 2021, 60, 149–163. [Google Scholar] [CrossRef]
- Plett, J.M. Order of microbial succession affects rhizobia-mediated biocontrol efforts against Phytophthora root rot. Microbiol. Res. 2021, 242, 126–628. [Google Scholar] [CrossRef]
- Okamoto, H.; Sato, M.; Sato, Z.; Isaka, M. Biocontrol of Phytophthora capsici by Serratia marcescens F-1-1 and analysis of biocontrol mechanisms using transposon-insertion mutants. Ann. Phytopathol. Soc. Jpn. 1998, 64, 287–293. [Google Scholar] [CrossRef]
- Segarra, G.; Avilés, M.; Casanova, E.; Borrero, A.; Trillas, I. Effectiveness of biological control of Phytophthora capsici in pepper by Trichoderma asperellum strain T34. Phytopathol. Mediterr. 2013, 52, 77–83. [Google Scholar] [CrossRef]
- Diánez, F.; Santos, M.; Carretero, F.; Marín, F. Trichoderma saturnisporum, a new biological control agent. J. Sci. Food Agric. 2016, 96, 1934–1944. [Google Scholar] [CrossRef]
- Chemeltorit, P.P.; Mutaqin, K.H.; Widodo, W. Combining Trichoderma hamatum THSW13 and Pseudomonas aeruginosa BJ10–86: A synergistic chili pepper seed treatment for Phytophthora capsici infested soil. Eur. J. Plant Pathol. 2017, 147, 157–166. [Google Scholar] [CrossRef]
- de Oliveira, T.A.S.; Blum, L.E.B.; Duarte, E.A.A.; Luz, E.D.M.N. Control of Phytophthora palmivora on postharvest papaya with Trichoderma asperellum, T. virens, T. harzianum and T. longibrachiatum. Bioscience 2018, 34, 1513–1521. [Google Scholar] [CrossRef]
- Tomah, A.A.; Abd Alamer, I.S.; Li, B.; Zhang, J.Z. A new species of Trichoderma and gliotoxin role: A new observation in enhancing biocontrol potential of T. virens against Phytophthora capsici on chili pepper. Biol. Cont. 2020, 145, 104–261. [Google Scholar] [CrossRef]
- Gilardi, G.; Pugliese, M.; Gullino, M.L.; Garibaldi, A. Effect of biocontrol agents and potassium phosphite against Phytophthora crown rot, caused by Phytophthora capsici, on zucchini in a closed soilless system. Sci. Hortic. 2020, 265, 109–207. [Google Scholar] [CrossRef]
- La Spada, F.; Stracquadanio, C.; Riolo, M.; Pane, A.; Cacciola, S.O. Trichoderma counteracts the challenge of Phytophthora nicotianae cnfections on tomato by modulating plant defense mechanisms and the expression of crinkler, necrosis-inducing Phytophthora Protein 1, and cellulose-Binding Elicitor Lectin Pathogenic Effectors. Front. Plant Sci. 2020, 11, 539–583. [Google Scholar] [CrossRef]
- Kang, S.W.; Kim, S.W. New antifungal activity of penicillic acid against Phytophthora species. Biotechnol. Lett. 2004, 26, 695–698. [Google Scholar] [CrossRef] [PubMed]
- El-Sayed, A.S.A.; Ali, G.S. Aspergillus flavipes is a novel efficient biocontrol agent of Phytophthora parasitica. Biol. Cont. 2020, 140, 72–104. [Google Scholar] [CrossRef]
- Wang, H.; Shi, J.; Luo, Z.; Chen, Q.; Wang, C. Isolation and identification of Penicillium strain QMYCS-2 and its effect on tobacco black shank Tobacco. Sci. Technol. Stud. 2020, 49, 2663. [Google Scholar] [CrossRef]
- Mondol, M.A.M.; Farthouse, J.; Islam, M.T.; Schüffler, A.; Laatsch, H. Metabolites from the Endophytic Fungus Curvularia sp. M12 Act as Motility Inhibitors against Phytophthora capsici zoospores. J. Nat. Prod. 2017, 80, 347–355. [Google Scholar] [CrossRef]
- Chen, J.T.; Su, H.J.; Huang, J.W. Isolation and identification of secondary metabolites of Clitocybe nuda responsible for inhibition of zoospore germination of Phytophthora capsici. J. Agric. Food Chem. 2012, 60, 7341–7344. [Google Scholar] [CrossRef]
- Santos, M.; Diánez, F.; Moreno-Gavíra, A.; Sánchez-Montesinos, B.; Gea, F.J. Cladobotryum mycophilum as potential biocontrol agent. Agronomy 2019, 9, 891. [Google Scholar] [CrossRef]
- Iqbal, M.; Jamshaid, M.; Zahid, M.A.; Vetukuri, R.R.; Stenberg, J.A. Biological control of strawberry crown rot, root rot and grey mould by the beneficial fungus Aureobasidium pullulans. Bio. Cont. 2021, 66, 535–545. [Google Scholar] [CrossRef]
- Safitri, D.; Wiyono, S.; Soekarno, B.P.W. Mode of action of the endophytic yeast Rhodotorula mucilaginosa in controlling basal stem rot caused by Phytopthora capsici. IOP Conf. Ser. Earth Environ. Sci. 2021, 667, 12–50. [Google Scholar] [CrossRef]
- Mercier, D.C. Manker Biocontrol of soil-borne diseases and plant growth enhancement in greenhouse soilless mix by the volatile producing fungus Muscodor albus. Crop. Prot. 2005, 24, 355–362. [Google Scholar] [CrossRef]
- Pozo, M.J.; Cordier, C.; Dumas-Gaudot, E.; Barea, J.M.; Azcón-Aguilar, C. Localized versus systemic effect of arbuscular mycorrhizal fungi on defence responses to Phytophthora infection in tomato plants. J. Exp. Bot. 2002, 53, 525–534. [Google Scholar] [CrossRef]
- Hu, J.; Hou, S.; Li, M.; Wu, F.; Lin, X. The better suppression of pepper Phytophthora blight by arbuscular mycorrhizal (AM) fungus than Purpureocillium lilacinum alone or combined with AM fungus. J. Soils Sed. 2020, 20, 792–800. [Google Scholar] [CrossRef]
- González-Hernández, A.I.; Suárez-Fernández, M.B.; Pérez-Sánchez, R.; Gómez-Sánchez, M.Á.; Morales-Corts, M.R. Compost tea induces growth and resistance against Rhizoctonia solani and Phytophthora capsici in pepper. Agronomy 2021, 11, 781. [Google Scholar] [CrossRef]
- Manasfi, Y.; Cannesan, M.A.; Riah, W.; Vicré, M.; Trinsoutrot-Gattin, I. Potential of combined biological control agents to cope with Phytophthora parasitica, a major pathogen of Choisya ternata. Eur. J. Plant Pathol. 2018, 152, 1011–1025. [Google Scholar] [CrossRef]
- Marín, F.; Diánez, F.; Santos, M.; Navarro, M.J.; Yau, J.A. Control of Phytophthora capsici and Phytophthora parasitica on pepper (Capsicum annuum L.) with compost teas from different sources, and their effects on plant growth promotion. Phytopathol. Med. 2014, 53, 216–228. [Google Scholar] [CrossRef]
- Diánez, F.; Santos, M.; Tello, J.C. Suppressive effects of grape marc compost on phytopathogenic oomycetes. Arch. Phytopathol. Pflanzenschutz 2007, 40, 1–18. [Google Scholar] [CrossRef]
- Fontana, D.C.; de Paula, S.; Torres, A.G.; Schmidt, D.; Neto, D.D. Endophytic fungi: Biological control and induced resistance to phytopathogens and abiotic stresses. Pathogens 2021, 10, 570. [Google Scholar] [CrossRef]
- Yyani, M.E.; Requena, C.; Egea-Gilabert, M.E. Candela biological control of Phytophthora root rot of pepper using Trichoderma harzianum and Streptomyces rochei in combination. J. Phytopathol. 2007, 155, 342–349. [Google Scholar] [CrossRef]
- Jiang, H.; Zhang, L.; Zhang, J.Z.; Ojaghian, M.R.; Hyde, K.D. Antagonistic interaction between Trichoderma asperellum and Phytophthora capsici in vitro. J. Zhejiang Univ. Sci. B 2016, 17, 271–281. [Google Scholar] [CrossRef]
- Trotta, A.; Varese, G.C.; Gnavi, E.; Fusconi, A.; Sampò, S.; Berta, G. Interactions between the soilborne root pathogen Phytophthora nicotianae var.parasitica and the arbuscular mycorrhizal fungus Glomus mosseae in tomato plants. Plant Soil 1996, 185, 199–209. [Google Scholar] [CrossRef]
- Phoka, N.; Suwannarach, N.; Lumyong, S.; Ito, S.; Matsui, K.; Arikit, S.; Sunpapao, A. Role of volatiles from the endophytic fungus Trichoderma asperelloides PSU-P1 in biocontrol potential and in promoting the plant growth of Arabidopsis thaliana. J. Fungi 2020, 6, 341. [Google Scholar] [CrossRef]
- Jin, J.H.; Zhang, H.X.; Tan, J.Y.; Yan, M.J.; Li, D.W.; Khan, A. A new ethylene-responsive factor CaPTI1 gene of pepper (Capsicum annuum L.) involved in the regulation of defense response to Phytophthora capsici. Front. Plant Sci. 2015, 6, 1217. [Google Scholar] [CrossRef] [PubMed]
- Lee, S.C.; Hwang, B.K. Induction of some defense-related genes and oxidative burst is required for the establishment of systemic acquired resistance in Capsicum annuum. Planta 2005, 221, 790–800. [Google Scholar] [CrossRef]
- El-Sayed, A.S.A.; Akbar, A.; Iqrar, I. A glucanolytic Pseudomonas sp. associated with Smilax bona-nox L. displays strong activity against Phytophthora parasitica. Microbiol. Res. 2018, 207, 140–152. [Google Scholar] [CrossRef]
- Shobha, M.S.; Mahadeva, M.S. Effect of Endophytic and plant growth promoting rhizobacteria against foot rot disease of Piper nigrum L. Int. J. Environ. Agric. Biotechnol. 2018, 3, 6. [Google Scholar] [CrossRef]
- Spence, C.; Alff, E.; Johnson, C.; Ramos, C.; Donofrio, N.; Sundaresan, V.; Bais, H. Natural rice rhizospheric microbes suppress rice blast infections. BMC Plant Biol. 2014, 14, 130. [Google Scholar] [CrossRef]
- Zhang, J.; Zhou, J.M. Plant immunity triggered by microbial molecular signatures. Mol. Plant 2010, 3, 783–793. [Google Scholar] [CrossRef]
- Saijo, Y.; Loo, E.P.; Yasuda, S. Pattern recognition receptors and signaling in plant–microbe interactions. Plant J. 2018, 93, 592–613. [Google Scholar] [CrossRef] [PubMed]
- Dong, X.; Ai, G.; Xia, C.; Pan, W.; Yin, Z.; Dou, D. Different requirement of immunity pathway components by oomycete effectors-induced cell death. Phytopathol. Res. 2022, 4, 4. [Google Scholar] [CrossRef]
- Dou, D.L.; Zhou, J.M. Phytopathogen effectors subverting host immunity: Different foes, similar battleground. Cell Host Microbe 2012, 12, 484–495. [Google Scholar] [CrossRef]
- Silvar, C.; Merino, F.; Díaz, J. Resistance in pepper plants induced by Fusarium oxysporum f. sp. lycopersici involves different defence-related genes. Plant Biol. 2009, 11, 68–74. [Google Scholar] [CrossRef]
- Stamler, R.A.; Holguin, O.; Dungan, B.; Goldberg, N.; Randall, J.J. BABA and Phytophthora nicotianae induce resistance to Phytophthora capsici in chile pepper (Capsicum annuum). PLoS ONE 2015, 10, e0128327. [Google Scholar] [CrossRef] [PubMed]
- Pieterse, C.M.J.; Zamioudis, C.B.R.L.; Weller, D.M.; Van Wees, S.C.M.; Bakker, P.A.H.M. Induced systemic resistance by beneficial microbes. Ann. Rev. Phytopathol. 2014, 52, 347–375. [Google Scholar] [CrossRef] [PubMed]
- Das, K.; Roychoudhury, A. Reactive oxygen species (ROS) and response of antioxidants as ROS-scavengers during environmental stress in plants. Front. Environ. Sci. 2014, 2, 53. [Google Scholar] [CrossRef]
- Savitha, M.J.; Sriram, S. Induced systemic resistance (ISR) in hot pepper against Phytophthora capsici infection triggered by cell wall oligosaccharide elicitors from Trichoderma species. Indian J. Hortic. 2017, 74, 233–239. [Google Scholar] [CrossRef]
- Sriram, S.; Manasa, S.B.; Savitha, M.J. Potential use of elicitors from Trichoderma in induced systemic resistance for the management of Phytophthora capsici in red pepper. J. Biol. Cont. 2009, 23, 449–456. [Google Scholar] [CrossRef]
- Umadevi, P.; Anandaraj, M. Proteomic analysis of the tripartite interaction between black pepper, Trichoderma harzianum and Phytophthora capsici provides insights into induced systemic resistance mediated by Trichoderma spp. Eur. J. Plant Pathol. 2019, 154, 607–620. [Google Scholar] [CrossRef]
- Bellini, A.; Pugliese, M.; Guarnaccia, V.; Meloni, G.R.; Gullino, L.M. Calcium oxide, potassium phosphite and a Trichoderma enriched compost water suspension protect Capsicum annuum against Phytophthora capsici by priming the immune system. Pest Manag. Sci. 2021, 77, 3484–3490. [Google Scholar] [CrossRef] [PubMed]
- Chowdappa, P.; Mohan Kumar, S.P.; Jyothi Lakshmi, M.; Upreti, K.K. Growth stimulation and induction of systemic resistance in tomato against early and late blight by Bacillus subtilis OTPB1 or Trichoderma harzianum OTPB3. Biol. Cont. 2013, 65, 109–117. [Google Scholar] [CrossRef]
- Qiu, Y.; Yan, H.H.; Sun, S.M.; Wang, Y.Q.; Zhao, X.R.; Wang, H.Y. Use of Bacillus velezensis SDTB022 against tobacco black shank (TBS) and the biochemical mechanism involved. Biol. Cont. 2022, 165, 104–785. [Google Scholar] [CrossRef]
- Yarullina, L.G.; Sorokan, A.V.; Tsvetkov, V.O.; Burkhanova, G.F.; Kalatskaja, J.N. Influence of the genus Bacillus bacteria on the content of H2O2 and the activity of hydrolases and their inhibitors in potato plants during Phytophthora infestans Mont. de Bary infection. BIO Web Conf. 2020, 23, 02010. [Google Scholar] [CrossRef]
- Sorokan, A.; Benkovskaya, G.; Burkhanova, G.; Blagova, D.; Maksimov, I. Endophytic strain Bacillus subtilis 26DCryChS producing Cry1Ia toxin from Bacillus thuringiensis promotes multifaceted potato defense against Phytophthora infestans (Mont.) de Bary and pest Leptinotarsa decemlineata Say. Plants 2020, 9, 1115. [Google Scholar] [CrossRef]
- Park, J.W.; Balaraju, K.; Kim, J.W.; Lee, S.W.; Park, K. Systemic resistance and growth promotion of chili pepper induced by an antibiotic producing Bacillus vallismortis strain BS07. Biol. Cont. 2013, 65, 246–257. [Google Scholar] [CrossRef]
- Lee, B.D.; Dutta, S.; Ryu, H.; Suh, D.S.; Park, K. Induction of systemic resistance in panax ginseng against Phytophthora cactorum by native Bacillus amyloliquefaciens HK34. J. Ginseng Res. 2015, 39, 213–220. [Google Scholar] [CrossRef]
- Kang, S.M.; Hamayun, M.; Waqas, M.; Shinwari, Z.K.; Lee, I.J. Burkholderia sp. KCTC 11096BP modulates pepper growth and resistance against Phytophthora capsici. Pak. J. Bot. 2016, 48, 1965–1970. [Google Scholar]
- Sang, M.K.; Kim, J.G.; Kim, K.D. Biocontrol activity and induction of systemic resistance in pepper by compost water extracts against Phytophthora capsici. Phytopathology 2010, 100, 774–783. [Google Scholar] [CrossRef]
- Ferrusquía-Jiménez, N.I.; Serrano-Jamaica, L.M.; Martínez-Camacho, J.E.; Sáenz de la O, D.; Villagomez-Aranda, A.L.; González-Chavira, M.M.; Guerrero-Aguilar, B.Z.; Torres-Pacheco, I.; Feregrino-Pérez, A.A.; Medina-Ramos, G.; et al. Extracellular self-DNA plays a role as a damage-associated molecular pattern (DAMP) delaying zoospore germination rate and inducing stress-related responses in Phytophthora capsici. Plant Pathol. 2022, 71, 1066–1075. [Google Scholar] [CrossRef]
- Analisis de la Campaña Hortofruticola. Campaña 2020/21. Cajamar. Available online: https://publicacionescajamar.es/publicacionescajamar/public/pdf/series-tematicas/informes-coyuntura-analisis-de-campana/informe-71-campana-almeria-20-21.pdf (accessed on 10 March 2023).
- Sánchez-Montesinos, B.; Diánez, F.; Moreno-Gavíra, A.; Gea, F.J.; Santos, M. Plant growth promotion and biocontrol of Pythium ultimum by saline tolerant Trichoderma isolates under salinity stress. Int. J. Environ. Res. Public Health 2019, 16, 2053. [Google Scholar] [CrossRef] [PubMed]
- Sánchez-Montesinos, B.; Santos, M.; Moreno-Gavíra, A.; Marín-Rodulfo, T.; Gea, F.J.; Diánez, F. Biological control of fungal diseases by Trichoderma aggressivum f. europaeum and its compatibility with fungicides. J. Fungi 2021, 7, 598. [Google Scholar] [CrossRef] [PubMed]
- Moreno-Gavíra, A.; Diánez, F.; Sánchez-Montesinos, B.; Santos, M. Paecilomyces variotii as a plant-growth promoter in horticulture. Agronomy 2020, 10, 597. [Google Scholar] [CrossRef]
- Santos, M.; Dianez, F.; Gonzalez del Valle, M.; Tello, J.C. Grape marc compost: Microbial studies and suppression of soil-borne mycosis in vegetable seedlings. World J. Microbiol. Biotechnol. 2008, 24, 1493–1505. [Google Scholar] [CrossRef]
- Diánez, F.; Boix, A.; de Cara, M.; Trillas, I.; Avilés, M.; Tello, J.C. Grape marc compost tea suppressiveness to plant pathogenic fungi: Role of siderophores. Compost. Sci. Util. 2006, 14, 48–53. [Google Scholar] [CrossRef]
- Sánchez-Montesinos, B.; Diánez, F.; Moreno-Gavira, A.; Gea, F.J.; Santos, M. Role of Trichoderma aggressivum f. europaeum as plant-growth promoter in horticulture. Agronomy 2020, 10, 1004. [Google Scholar] [CrossRef]
- Ling, Q.; Huang, W.; Jarvis, P. Use of a SPAD-502 meter to measure leaf chlorophyll concentration in Arabidopsis thaliana. Photosyn. Res. 2011, 107, 209–214. [Google Scholar] [CrossRef]
- Livak, K.J.; Schmittgen, T.D. Analysis of Relative Gene Expression Data Using Real-Time Quantitative PCR and the 2−ΔΔCT Method. Methods 2001, 25, 402–408. [Google Scholar] [CrossRef]
- Wang, J.E.; Li, D.W.; Zhang, Y.L.; Zhao, Q.; He, Y.M.; Gong, Z.H. Defence responses of pepper (Capsicum annuum L.) infected with incompatible and compatible strains of Phytophthora capsici. Eur. J. Plant Pathol. 2013, 136, 625–638. [Google Scholar] [CrossRef]
- Gayoso, C.; Martinez de ilarduya, O.; Pomar, F.; Merino, F. Assessment of real-time PCR as a method for determining the presence of Verticillium dahliae in different Solanaceae cultivars. Eur. J. Plant Pathol. 2007, 118, 199–209. [Google Scholar] [CrossRef]
- Lee, S.C.; Hwang, B.K. Identification of the pepper SAR8.2 gene as a molecular marker for pathogen infection, abiotic elicitors and environmental stresses in Capsicum annuum. Planta 2003, 216, 387–396. [Google Scholar] [CrossRef] [PubMed]
- Cheng, Y.; Pang, X.; Wan, H.; Ahammed, G.J.; Yu, J.; Yao, Z.; Ruan, M.; Ye, Q.; Li, Z.; Wang, R.; et al. Identification of optimal reference genes for normalization of qPCR analysis during pepper fruit development. Front. Plant Sci. 2017, 8, 1128. [Google Scholar] [CrossRef]
- Volynchikova, E.; Kim, K.D. Biological control of oomycete soilborne diseases caused by Phytophthora capsici, Phytophthora infestans, and Phytophthora nicotianae in Solanaceous crops. Mycobiology 2022, 50, 269–293. [Google Scholar] [CrossRef]
- Ren, Y.; Armstrong, M.; Qi, Y.; Mclellan, H.; Zhong, C.; Du, B. Phytophthora infestans RXLR effectors target parallel steps in an immune signal transduction pathway. Plant Physiol. 2019, 180, 2227–2239. [Google Scholar] [CrossRef]
- Moreno-Gavira, A.; Huertas, V.; Diánez, F.; Sánchez-Montesinos, B.; Santos, M. Paecilomyces and its importance in the biological control of agricultural pests and diseases. Plants 2020, 9, 1746. [Google Scholar] [CrossRef]
- Bononi, L.; Chiaramonte, J.B.; Pansa, C.C.; Moitinho, M.A.; Melo, I.S. Phosphorus-solubilizing Trichoderma spp. from Amazon soils improve soybean plant growth. Sci. Rep. 2020, 10, 2858. [Google Scholar] [CrossRef]
- Khan, R.A.A.; Najeeb, S.; Hussain, S.; Xie, B.; Li, Y. Bioactive secondary metabolites from Trichoderma spp. against phytopathogenic fungi. Microorganisms 2020, 8, 817. [Google Scholar] [CrossRef] [PubMed]
- Liu, Y.; He, P.; He, P.; Tian, Y.; He, Y. Potential biocontrol efficiency of Trichoderma species against oomycete pathogens. Front. Microbiol. 2022, 13, 974024. [Google Scholar] [CrossRef] [PubMed]
- Ros, M.; Raut, I.; Santisima-Trinidad, A.B.; Pascual, J.A. Relationship of microbial communities and suppressiveness of Trichoderma fortified composts for pepper seedlings infected by Phytophthora nicotianae. PLoS ONE 2017, 12, e0174069. [Google Scholar] [CrossRef] [PubMed]
- Choudhary, A.K.; Singh, N.; Singh, D. Evaluation of the bioformulation of potent native strains of Trichoderma spp. against the foot rot/gummosis of Kinnow mandarin. Egypt J. Biol. Pest Cont. 2021, 31, 90. [Google Scholar] [CrossRef]
- Roberts, D.P.; Maul, J.E.; McKenna, L.F.; Emche, S.E.; Meyer, S.L.F.; Collins, R.T.; Bowers, J.H. Selection of genetically diverse Trichoderma spp. isolates for suppression of Phytophthora capsici on bell pepper. Can. J. Microbiol. 2010, 56, 864–873. [Google Scholar] [CrossRef] [PubMed]
- Ezziyyani, M.; Pérez Sánchez, C.; Sid Ahmed, A.; Requena, M.E.; Candela, M.E. Trichoderma harzianum como biofungicida para el biocontrol de Phytophthora capsici en plantas de pimiento (Capsicum annuum L.). Anal. Biol. 2004, 26, 35–45. [Google Scholar]
- Li, M.F.; Li, G.H.; Zhang, K.Q. Non-volatile metabolites from Trichoderma spp. Metabolites 2019, 9, 58. [Google Scholar] [CrossRef] [PubMed]
- Lee, S.; Yap, M.; Behringer, G.; Hung, R.; Joan, W.B. Volatile organic compounds emitted by Trichoderma species mediate plant growth. Fungal Biol. Biotechnol. 2016, 3, 7. [Google Scholar] [CrossRef] [PubMed]
- Li, X.Q.; Kuo, X.; Liu, X.M.; Zhang, P. A systematic review on secondary metabolites of paecilomyces species: Chemical diversity and biological activity. Planta Med. 2020, 86, 805–821. [Google Scholar] [CrossRef] [PubMed]
- Bae, S.J.; Mohanta, T.K.; Chung, J.Y.; Ryu, M.; Park, G.; Shim, S.; Hong, S.B.; Seo, H.; Bae, D.W.; Bae, I.; et al. Trichoderma metabolites as biological control agents against Phytophthora pathogens. Biol. Cont. 2016, 92, 128–138. [Google Scholar] [CrossRef]
- Dai, Z.B.; Wang, X.; Li, G.H. Secondary metabolites and their bioactivities produced by Paecilomyces. Molecules 2020, 25, 5077. [Google Scholar] [CrossRef]
- Moreno-Gavíra, A.; Diánez, F.; Sánchez-Montesinos, B.; Santos, M. Biocontrol effects of Paecilomyces variotii against fungal plant diseases. J. Fungi 2021, 7, 415. [Google Scholar] [CrossRef]
- Sood, M.; Kapoor, D.; Kumar, V.; Sheteiwy, M.S.; Ramakrishnan, M.; Landi, M. Trichoderma: The “secrets” of a multitalented biocontrol agent. Plants 2020, 9, 762. [Google Scholar] [CrossRef]
- Jung, H.W.; Hwang, B.K. Pepper gene encoding a basic b-1,3-glucanase is differentially expressed in pepper tissues upon pathogen infection and ethephon or methyl jasmonate treatment. Plant Sci. 2000, 156, 23–34. [Google Scholar] [CrossRef]
- Kim, Y.J.; Hwang, B.K. Pepper gene encoding a basic pathogenesis-related 1 protein is pathogen and ethylene inducible. Physiol. Plantarum 2000, 108, 51–60. [Google Scholar] [CrossRef]
- Kang, D.S.; Min, K.J.; Kwak, A.M.; Lee, S.Y.; Kang, H.W. Defense response and suppression of Phytophthora blight disease of pepper by water extract from spent mushroom substrate of Lentinula edodes. Plant Pathol. J. 2017, 33, 264–275. [Google Scholar] [CrossRef] [PubMed]
- Gutierrez, N.; Giménez, M.J.; Torres, A.M.; Atienza, S.G.; Avila, C.M.; Palomino, C. Up-regulation of resistance gene analogs (RGA) in chickpea in the early response to Fusarium wilt. Euphytica 2012, 186, 793–804. [Google Scholar] [CrossRef]
- Silvar, C.; Merino, F.; Díaz, J. Differential activation of defense-related genes in susceptible and resistant pepper cultivars infected with Phytophthora capsici. J. Plant Physiol. 2008, 165, 1120–1124. [Google Scholar] [CrossRef]
- Sarowar, S.; Kim, Y.J.; Kim, E.N. Overexpression of a pepper basic pathogenesis-related protein 1 gene in tobacco plants enhances resistance to heavy metal and pathogen stresses. Plant Cell Rep. 2005, 24, 216–224. [Google Scholar] [CrossRef]
- Shi, R.; Jin, J.; Nifong, J.M.; Shew, D.; Lewis, R.S. Homoeologous chromosome exchange explains the creation of a QTL affecting soil-borne pathogen resistance in tobacco. Plant Biotechnol. J. 2022, 20, 47–58. [Google Scholar] [CrossRef]
Disclaimer/Publisher’s Note: The statements, opinions and data contained in all publications are solely those of the individual author(s) and contributor(s) and not of MDPI and/or the editor(s). MDPI and/or the editor(s) disclaim responsibility for any injury to people or property resulting from any ideas, methods, instructions or products referred to in the content. |
© 2023 by the authors. Licensee MDPI, Basel, Switzerland. This article is an open access article distributed under the terms and conditions of the Creative Commons Attribution (CC BY) license (https://creativecommons.org/licenses/by/4.0/).